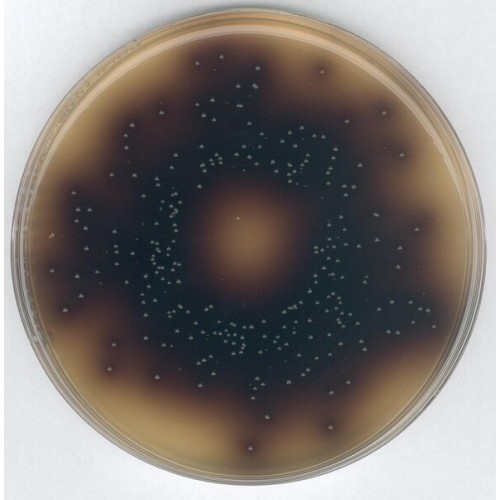

BILIS ESULINA AZIDA AGAR, SEGUNDO ISO 7899-2 MERCK - EMB 500G
Modelo: 1000720500
-
R$1.340,76
ou até 3x de R$446,92 sem juros
Economize 5% no PIX: R$1.273,72
ou 3.5% no boleto: R$1.293,83
Descrição
BILE ESULIN AZIDE AGAR MERCK,
RENDIMENTO 54,65g/l ,SEGUNDO ISO 7899-2
Embalagem 500g.
Typical Composition (g/litre)
Peptone from Casein 17.0; peptone 3.0; yeast extract 5.0; sodium chloride 5.5; aesculin 1.0; ammonium iron(III) citrate 0.5; ox bile 10.0; sodium azide 0.15; agar-agar 13.0:
Preparation
Suspend 54.65 g in 1 litre water and dissolve by boiling. Sterilise for 15 min. at 121 °C. After cooling to 45-50 °C pour into Petridishes to a depth of 3 mm to 5 mm and allow to solidify. pH: 7.1 ± 0.2 at 25 °C. The plates are clear and yellow.
Poured plates can be stored at +2 - +8°C for up to 2 weeks.
RENDIMENTO 54,65g/l ,SEGUNDO ISO 7899-2
Embalagem 500g.
Typical Composition (g/litre)
Peptone from Casein 17.0; peptone 3.0; yeast extract 5.0; sodium chloride 5.5; aesculin 1.0; ammonium iron(III) citrate 0.5; ox bile 10.0; sodium azide 0.15; agar-agar 13.0:
Preparation
Suspend 54.65 g in 1 litre water and dissolve by boiling. Sterilise for 15 min. at 121 °C. After cooling to 45-50 °C pour into Petridishes to a depth of 3 mm to 5 mm and allow to solidify. pH: 7.1 ± 0.2 at 25 °C. The plates are clear and yellow.
Poured plates can be stored at +2 - +8°C for up to 2 weeks.
Etiquetas: bilie esulina azida agar, bile esulina para microbiologia